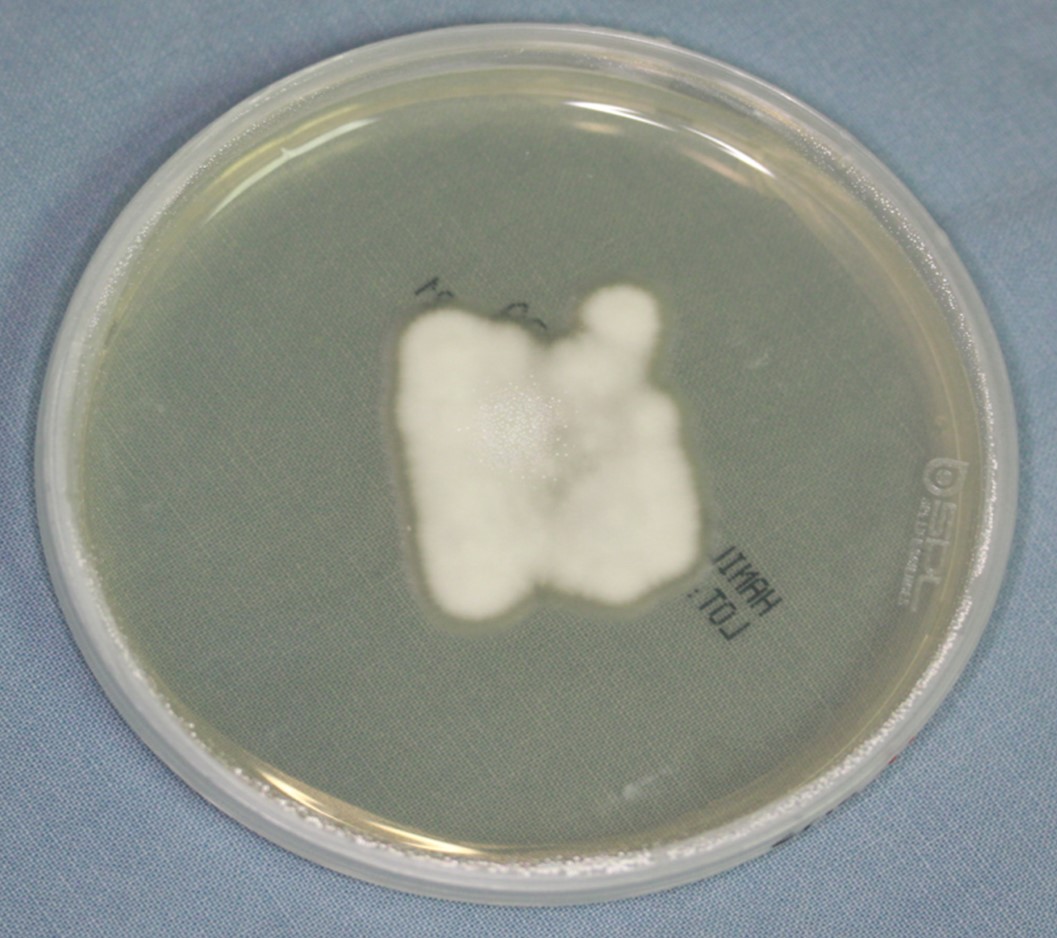

피부과적 치료법
발전된 의료 서비스를 위해 진료정보를 공유합니다.
No. 3325
|
배양검사
2015.12.17
작성자 : 관리자
조회 : 7029
|
|
|---|---|
|
배양검사
배양검사란 피부에 곰팡이 감염을 일으킨 의심균을 얻어내어 확진하는 방법으로 세균 또는 진균이 자라기 좋은 조건을 준비하여 피부 병터로부터 검체를 체취하여 의심되는 균을 증식시켜 균 유무를 확인하고 균의 종류를 판별하는 검사법이다. (1) 세균배양 세균배양을 위한 재료는 터지지 않은 물집이나 고름물집에서 채집하고 딱지가 형성되어 있다면 먼저 딱지를 떼고 그 밑에 있는 삼출액을 닦아내어 배양한다. 연조직염에서는 식염수를 병터내로 주입하고 다시 흡인하여 얻은 액으로 원인균을 규명하기도 한다. (2) 진균배양 곰팡이의 배양에는 사브로덱스트로오스배지를 흔히 사용하며, 가검물을 채취할 때 의심되는 피부 병변의 각질이나, 물집의 상층을 굵어서 채취하거나 침범된 모발이나 손발톱을 모아서 배양한다. 배양은 실온이나 25℃에서 4주정도 관찰한다. 무좀의 흔한 원인균인 피부사상균은 곰팡이가 자라면 배지의 색깔이 황색에서 붉은색으로 변하여 병원성 곰팡이가 자라는지를 쉽게 알 수 있다.
그림. 진균 배양
김진우, 이철헌. 피부의 증상, 징후와 진단, In: 대한피부과학회 교과서 편찬위원회. 피부과학. 개정6판. 서울: 대한의학서적, 2014:59
|
| 이전글 | 보습제 | 2015.12.17 |
| 다음글 | 모발이식술 | 2015.12.11 |
대한피부과학회는 정보통신망법 제 50조의 2, 제50조의 7 등에 의거하여, 대한피부과학회가 운영, 관리하는 웹페이지상에서, 이메일주소 수집 프로그램이나 그 밖의 기술적 장치 등을 이용하여 이메일 주소를 무단으로 수집하는 행위를 거부합니다.
[게시일 2020년 5월 15일]